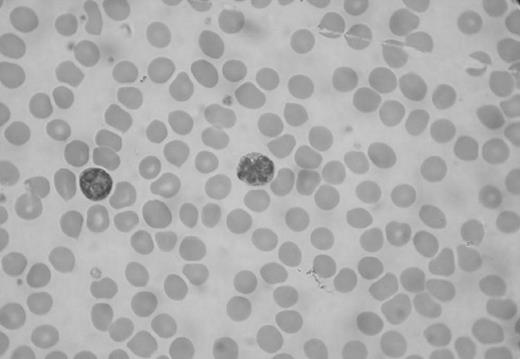
Figure

Abstract
Introduction: ATLL) is a postthymic lymphoproliferative neoplasm of T cells caused by human T-cell lymphotropic virus (HTLV-1). Most cases are found in Japan, the Caribbean basin, and West Africa.ATLL is essentially a disease of adults, characterized by generalized lymphadenopathy, hepatosplenomegaly, skin lesions, and hypercalcemia. The prognosis of most patients is quite poor, with a median survival time of only 13 months, even with combination chemotherapy. The acute form had a significantly shorter survival (2 months) than lymphoma type (13 months)Advanced performance status, high lactic dehydrogenase, age > 40 years, increased total involved lesions and hypercalcemia, are associated with shortened survival (p<0.01). Hypercalcemia is observed in >80% of ATL. CASE Report:A 43 years old carribean male presented with refractory hypercalcemia 18 g/dl wihtout hematological manifestations,lymphadenopathy or hepatosplenomegaly. He had normal skeletal survey,serum immunoglobulins,immunofixation.The patient also had normal PTH,PTHrp,Vitamin D3,angiotensin converting enzyme levels and 24 hour urinary calcium.The patient had Hemoglobin 13.5 and absolute lymphocytosis 5000–6000/cubic mm.Peripheral smear showed clover T cells Bone marrow had normal morphology but flow cytometry revealed T cells immunoreactive for CD3, CD4,CD8, CD5, and CD25 and were nonimmunoreactive for CD7 .The patient developed visual disturbances, swllowing difficulty and facial palsy during hospital stay.MRI brain was normal but CSF flow cytometry was positive for CD2, CD3, CD4, CD8,CD5, and CD25 and were negative for CD7. Cytogenetic studies showed complex karyotype with: 47, XY,add(4)(p12),+add(4)(p12),add(5)(q11.2),add(7)(q31),–12,Add(12)(q22),der(13)t(5;13)(q11.2;q22),add(14)(q32),add(17)(q23) +mar1(11)/48,idem,+mar1(5)/46,XY(4).A Hyperdiploid male karyotype with monosomy for chromosome No.12,unbalanced translocation involving the long chromosome Nos. 5 and 13, additional material on long arm of 5,7, 12, 14(14q+chromosome) and 17 Complex karyotypes with numerical and structural abnormalities with six or more breaks involving the long arms of chromosomes Nos. 1, 3,6,7,12 and 14q 32 and the short arm of chromosome Nos. 10, 17 and 21 are reported in ATLL .T cell gene rearrangement confirmed the diagnosis.The patient had history of Strongyloides stercoralis infection 8 years ago.He was HIV negativebut had HTLV-1 antibodies(gp19,gp21).He was treated with EPOCH regimen along with intrathecal treatment with normal repeat cytology and CSF flow cytometry.The patientis planned for allogeneic transplant after completion of chemotherapy.
Discussion: Adult T-cell lymphoma virus type 1, is implicated diseases including HTLV 1 associated myelopathy,Strongyloides stercoralis hyperinfection, and adult T leukemia/lymphoma. The virus activates a subset of T helper Th1cells with suppression of the Th2 lymphocytes and a reduction of Th2 cytokine production of IL-4, IL-5, IL-10 and IL-13 with an inadequate immune response to invading parasitic infections such as Strongyloides stercoralis. Dual positivity for CD4 and CD8 cells thus confers better prognosis.
Author notes
Disclosure: No relevant conflicts of interest to declare.
This feature is available to Subscribers Only
Sign In or Create an Account Close Modal